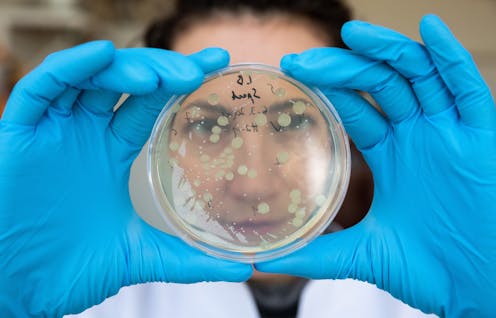

Calling the latest gene technologies 'natural' is a semantic distraction — they must still be regulated
- Written by Jack Heinemann, Professor of Molecular Biology and Genetics, University of Canterbury
Legislators around the world are being asked to reconsider how to regulate the latest developments in gene technology, genome editing and gene silencing.
Both the European Court of Justice and the New Zealand High Court have ruled that genome editing techniques should remain under the regulations specific to genetically modified organisms.
But a few other countries, including Australia, have exempted some uses of these techniques from their regulations, based on similarities to what occurs in nature. The main argument is that the biochemical processes of editing are like the processes that cause natural mutations.
The “equivalent to nature” narrative blurs the boundary between natural processes and technology.
Unfortunately, the risks from technology don’t disappear by calling it natural. The risk of harm from gene technology accumulates over time and scale of production. In our new research, we propose a framework that regulates technologies depending on their scale of use.
Proponents of deregulation of gene technology use the naturalness argument to make their case. But we argue this is not a good basis for deciding whether a technology should be regulated.
Read more: Human gene editing: who decides the rules?
Risk of harm grows with increased use
The notion of naturalness has been criticised as unscientific in the past, but now some scientists are using it to say that gene editing should be exempt from regulations.
Geneticists have long used the term “spontaneous” to refer to events that are outside of human control. Mutations can be either spontaneous or caused by people using gene technology. Differences in DNA sequences produced by either might give rise to a new trait.
In nature, if a new trait brings an advantage to the organism, it is amplified through reproductive fitness. When humans amplify a trait through selective breeding, we substitute our hands for the invisible hands of natural selection. We therefore create additional potential for harm through our interventions.
Some uses and outcomes of gene technology can be made to appear natural, but this is a diversion from how and why gene technology should be regulated. Instead we should recognise that gene technologies allow more people to produce and amplify modified organisms more quickly and in more environments.
Any potential harmful outcomes of the use of gene technology increase as it is used more. What makes gene technology useful is also what makes it risky.
Complex risk
Nobel laureate Sydney Brenner described gene technology as a biological Archimedian lever for doing what could occur spontaneously in a faster, more concentrated and very different manner.
We now have the tools to speed up biological change and if this is carried out on a large enough scale, then we can say that if anything can happen it certainly will.
Safety increases with the use of some technologies, such as car brakes. The more cars with brakes, the safer our roads. No tool of gene technology, including gene silencing and genome editing, becomes safer the more it is used.
Gene technologies can be improved incrementally, but that isn’t making them safer when used more. Any potential risks multiply as more people use them more frequently and on more species. Regulation is our least imperfect tool to manage this risk.
Read more: COVID-19 and gene editing: ethical and legal considerations
Imagine if other technologies with the capacity to harm were governed by resemblance to nature. Should we deregulate nuclear bombs because the natural decay chain of uranium-238 also produces heat, gamma radiation and alpha and beta particles?
We inherently recognise the fallacy of this logic. The technology risk equation is more complicated than a supercilious “it’s just like nature” argument.
Critical control points
We proposed the use of critical control points in a governance framework to regulate technology consistently with its risk to cause harm.
One such critical control point is between the introduction of mutations and the release of the organism. Another is the decision to make genome editing and gene silencing reagents available for sale to nearly anyone.
Deregulation and tiered regulatory frameworks release important critical control points from oversight. That is a problem even for what might be considered low-risk uses of genome editing and gene silencing because if they are used more without regulatory oversight, the likelihood of harm increases.
Critical control points tether governance to risk rather than downplay risk using metaphors that sound like science but are not. “No foreign DNA” or “just like nature” are slippery semantics — they are not measurable but make risk assessments sound quantitative and precise.
This approach raises misunderstanding of the underlying causes of harm from technology, inviting Brenner’s future where “if anything can happen it certainly will”.
Whether it is by sweeping or creeping deregulation, carefully chosen metaphors descale the risk of any kind of genetic engineering. By sleight of speech any technology can be made to sound like an extension of nature.
Critical control points instead inform both risk assessment and risk mitigation with precision. Regulated gene technologies can produce safe and possibly socially acceptable products, but we don’t get to them faster by taking short cuts.
Authors: Jack Heinemann, Professor of Molecular Biology and Genetics, University of Canterbury